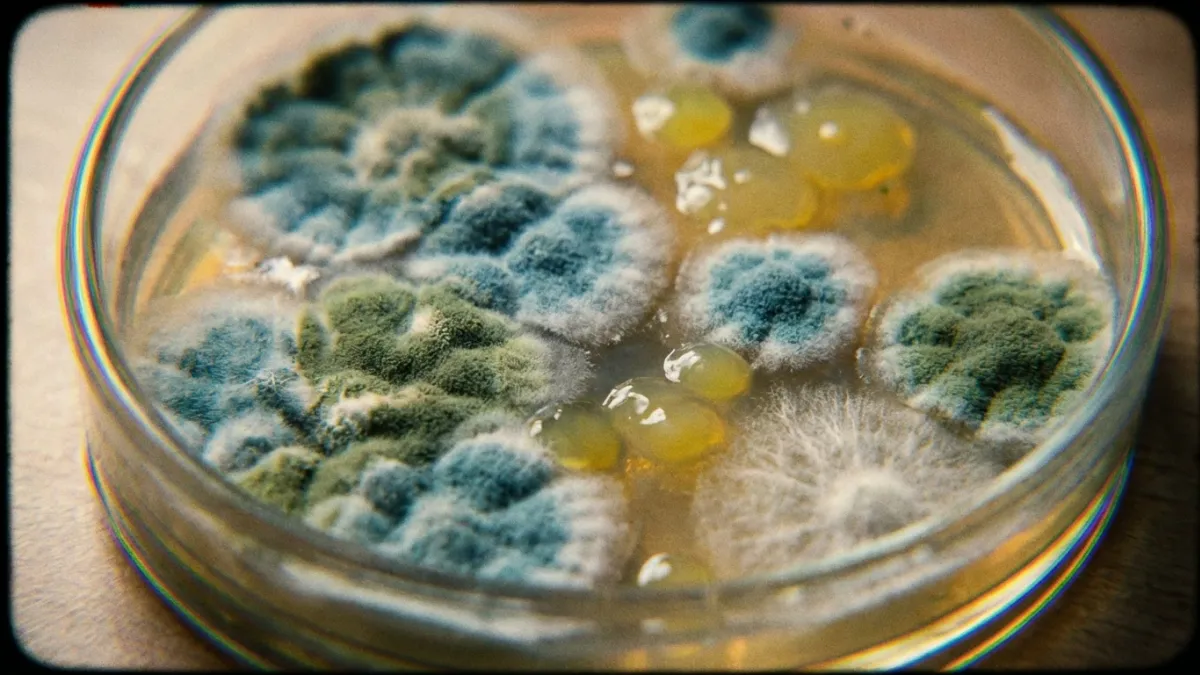

The Rifled Tunnel: Decoding Chirality-induced Spin Selectivity
Nature uses spiral-shaped molecules to filter electrons based on their magnetic spin, much like a rifled barrel directs a bullet. This quantum filtering effect suggests why biological systems transport energy so efficiently without overheating.
By Kumar, Gupta